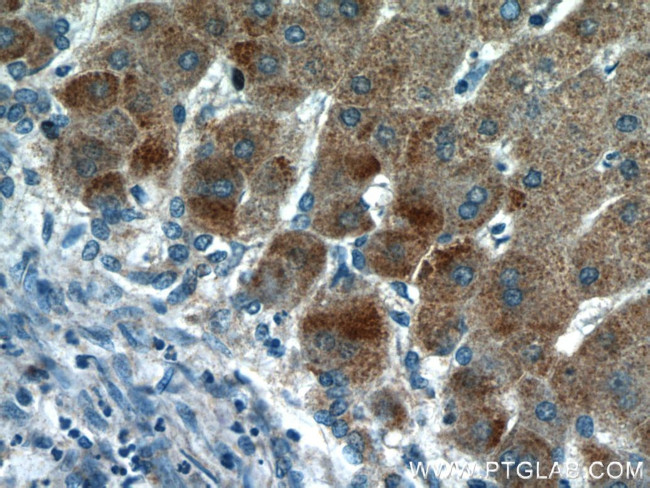
HBXIP Antibody in Immunohistochemistry (Paraffin) (IHC (P))
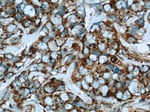
HBXIP Antibody in Immunohistochemistry (Paraffin) (IHC (P))
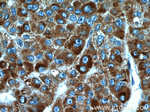
HBXIP Antibody in Immunohistochemistry (Paraffin) (IHC (P))
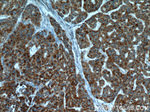
HBXIP Antibody in Immunohistochemistry (Paraffin) (IHC (P))

Search
Proteintech
HBXIP Polyclonal Antibody
{{$productOrderCtrl.translations['antibody.pdp.commerceCard.promotion.promotions']}}
{{$productOrderCtrl.translations['antibody.pdp.commerceCard.promotion.viewpromo']}}
{{$productOrderCtrl.translations['antibody.pdp.commerceCard.promotion.promocode']}}: {{promo.promoCode}} {{promo.promoTitle}} {{promo.promoDescription}}. {{$productOrderCtrl.translations['antibody.pdp.commerceCard.promotion.learnmore']}}
产品信息
14492-1-AP
种属反应
已发表种属
宿主/亚型
分类
类型
抗原
偶联物
形式
浓度
规格
纯化类型
保存液
内含物
保存条件
运输条件
产品详细信息
Immunogen sequence: MEPGAGHLD GHRAGSPSLR QALCDGSAVM FSSKERGRCT VINFVPLEAP LRSTPRSRQV TEACGGEGRA VPLGSEPEWS VGGMEATLEQ HLEDTMKNPS IVGVLCTDSQ GLNLGCRGTL SDEHAGVISV LAQQAAKLTS DPTDIPVVCL ESDNGNIMIQ KHDGITVAVH KMAS (1-173 aa encoded by BC062619)
靶标信息
HBXIP, also named as XIP, belongs to the HBXIP family. It is originally identified by its interaction with the C-terminus of hepatitis B virus (HBV) X protein (HBx). HBXIP is a regulator of centrosome dynamics and cytokinesis. HBXIP is able to up-regulate S100A4 though activating STAT4 and inducing DNA methylation of PTEN. HBXIP is a cellular 18kd protein and cytoplasm stain.
仅用于科研。不用于诊断过程。未经明确授权不得转售。
生物信息学
蛋白别名: HBV X-interacting protein; HBV X-interacting protein homolog; HBx-interacting protein; HBX-interacting protein homolog; HBXIP; hepatitis B virus x interacting protein; Hepatitis B virus X-interacting protein; hepatitis B virus x-interacting protein (9.6kD); hepatitis B virus X-interacting protein homolog; Late endosomal/lysosomal adaptor and MAPK and MTOR activator 5; MGC71071; Ragulator complex protein LAMTOR5; unnamed protein product
基因别名: 1110003H18Rik; HBXIP; LAMTOR5; XIP
UniProt ID: (Human) O43504, (Mouse) Q9D1L9
Entrez Gene ID: (Human) 10542, (Rat) 295357, (Mouse) 68576